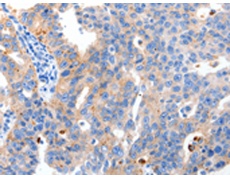
一抗

中文名稱: 兔抗MAPK10多克隆抗體
英文名稱: Anti-MAPK10 rabbit polyclonal antibody
別 名: JNK3, JNK3A, PRKM10, SAPK1b, p493F12, p54bSAPK
相關(guān)類別: 一抗
儲 存: 冷凍(-20℃)
宿 主: Rabbit
抗 原: MAPK10
反應種屬: Human, Mouse, Rat
標 記 物: Unconjugate
克隆類型: rabbit polyclonal
技術(shù)規(guī)格
|
Background: |
The protein encoded by this gene is a member of the MAP kinase family. MAP kinases act as an integration point for multiple biochemical signals, and are involved in a wide variety of cellular processes such as proliferation, differentiation, transcription regulation and development. This protein is a neuronal-specific form of c-Jun N-terminal kinases (JNKs). Through its phosphorylation and nuclear localization, this kinase plays regulatory roles in the signaling pathways during neuronal apoptosis. Beta-arrestin 2, a receptor-regulated MAP kinase scaffold protein, is found to interact with, and stimulate the phosphorylation of this kinase by MAP kinase kinase 4 (MKK4). Cyclin-dependent kianse 5 can phosphorylate, and inhibit the activity of this kinase, which may be important in preventing neuronal apoptosis. Four alternatively spliced transcript variants encoding distinct isoforms have been reported. |
|
Applications: |
ELISA, WB, IHC |
|
Name of antibody: |
MAPK10 |
|
Immunogen: |
Synthetic peptide of human MAPK10 |
|
Full name: |
mitogen-activated protein kinase 10 |
|
Synonyms: |
JNK3, JNK3A, PRKM10, SAPK1b, p493F12, p54bSAPK |
|
SwissProt: |
P53779 |
|
ELISA Recommended dilution: |
1000-5000 |
|
IHC positive control: |
Human breast cancer |
|
IHC Recommend dilution: |
5-20 |
|
WB Predicted band size: |
53 kDa |
|
WB Positive control: |
293T cells |
|
WB Recommended dilution: |
500-2000 |



 購物車
購物車 幫助
幫助
 021-54845833/15800441009
021-54845833/15800441009